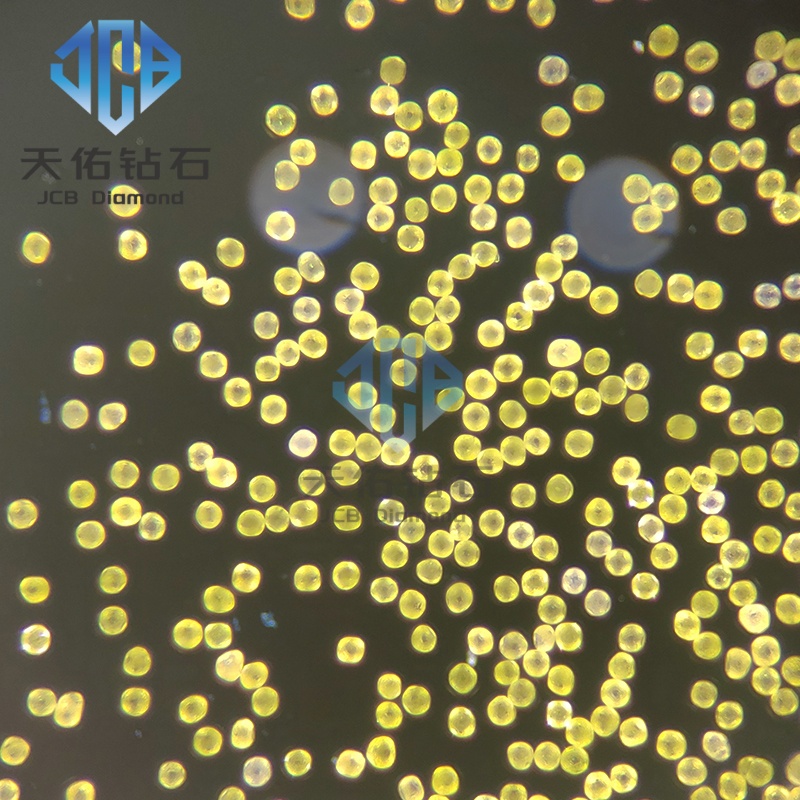
Сферический теплопроводящий алмаз

EN
Монокристальный материал Superhard
Поликристаллические материалы суперхарда
PCD поликристаллический бриллиант
Головка для волочения проволоки из натурального алмаза
Фильера для волочения проволоки из натурального алмаза, 25 x 8 мм, диаметр отверстия 0,165 мм
Ультратонкая волочильная головка для проволоки из натурального алмаза, апертура 0,007 мм
Матрица для волочения проволоки из натурального алмаза 0,014 мм для прецизионных применений
Ультратонкая фильера для волочения проволоки из натурального алмаза толщиной 0,016 мм
Ультратонкая фильера для волочения натуральных алмазов толщиной 0,020 мм
Высококачественная матрица из натурального алмаза диаметром 0,022 мм для волочения проволоки
Матрицы для волочения отверстий специальной формы из карбида вольфрама
MCD волоки для волочения проволоки
Сверхвысокоточные волоки MCD для волочения проволоки с зеркальной поверхностью
Долговечные волочильные матрицы MCD – срок службы в 10 раз дольше, чем у поликристаллических матриц
Матрицы MCD для волочения проволоки на заказ для отверстий любого размера от 0,015 мм до 10 мм
Изготовленная на заказ волока для волочения проволоки MCD диаметром от 0,015 до 10 мм
Экономичные волочильные матрицы MCD — от 9 долларов США за штуку за 0,20 мм, до 1000 готовых штук

Обзор продукта: Сферический теплопроводящий алмаз
Сферический алмаз — это высокоэффективный терморегулирующий материал с регулярной сферической или почти сферической морфологией. Он унаследовал сверхвысокую собственную теплопроводность алмаза, одновременно используя преимущества обработки сферической структуры. Этот материал отличается высокой удельной поверхностью, отличной адсорбционной способностью и легкостью наполнения. Размер его частиц колеблется от микрометров (например, 20 мкм) до сотен микрометров (например, 600 мкм).
В композиционных материалах сферический алмаз более равномерно диспергируется внутри матрицы, уменьшая межчастичные пустоты и межфазное термическое сопротивление, тем самым повышая общую теплопроводность. По сравнению с частицами неправильной формы, сферические частицы обеспечивают более плотную упаковку в полимерной или металлической матрице, значительно сводя к минимуму зазоры между частицами. Это приводит к снижению межфазного термического сопротивления во время теплопередачи, обеспечивая более эффективные пути теплового потока. Прочная межфазная связь сводит к минимуму тепловое рассеяние и потери энергии на границах раздела, позволяя эффективно передавать тепло от источника через алмазные частицы.
Основные методы приготовления
Постобработка сфероидизации
Технология постобработки: алмазные частицы неправильной формы и с острыми краями подаются в шаровую мельницу, где они подвергаются столкновению с воздухом под высоким давлением. Этот процесс изменяет форму краев и углов бриллиантов и постоянно повторяется для достижения желаемой сферичности.













